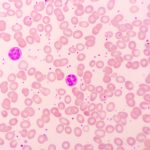
علت پایین بودن پلاکت خون

علت سرطان خون چیست و چگونه به وجود میآید؟
بسیاری از مردم تعجب میکنند که چه چیزی باعث سرطان خون میشود. مطالعات گستردهای در حال انجام شدن است، اما محققان هنوز دلایل دقیق این بیماری را شناسایی نکردهاند. بااینحال باید گفت دلالی زیادی باعث ایجاد سرطان میشود. علت سرطان خون میتواند به توجه به نوع سرطان خون، متفاوت باشد. برخی از عوامل نیز باعث […]